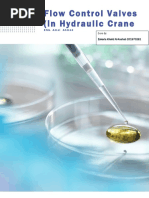

0% found this document useful (0 votes)
192 views31 pagesARM Cortex-M Instruction Guide
The document discusses arithmetic and logic instructions for ARM Cortex-M embedded systems. It provides an overview of shift, logic, bit set/clear, bit/byte reordering, addition, subtraction, multiplication, division, saturation, sign extension, and bit field extract instructions. It also covers data movement, commonly used arithmetic operations, and examples of add and set condition flag instructions. Finally, it briefly describes the ARM processor registers including the general purpose, stack pointer, link, and program counter registers as well as special purpose registers.
Uploaded by
zakariaCopyright
© © All Rights Reserved
We take content rights seriously. If you suspect this is your content, claim it here.
Available Formats
Download as PDF, TXT or read online on Scribd
0% found this document useful (0 votes)
192 views31 pagesARM Cortex-M Instruction Guide
The document discusses arithmetic and logic instructions for ARM Cortex-M embedded systems. It provides an overview of shift, logic, bit set/clear, bit/byte reordering, addition, subtraction, multiplication, division, saturation, sign extension, and bit field extract instructions. It also covers data movement, commonly used arithmetic operations, and examples of add and set condition flag instructions. Finally, it briefly describes the ARM processor registers including the general purpose, stack pointer, link, and program counter registers as well as special purpose registers.
Uploaded by
zakariaCopyright
© © All Rights Reserved
We take content rights seriously. If you suspect this is your content, claim it here.
Available Formats
Download as PDF, TXT or read online on Scribd
/ 31